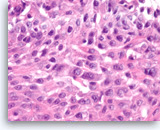
Image 3

Cellient Atlas - Pancreas FNA
INTRODUCTION
Guoping Cai, M.D.
Pancreatic lesions comprise a wide spectrum of entities, ranging from non-neoplastic to neoplastic lesions, and benign to malignant neoplasms [1]. Accurate preoperative diagnosis of pancreatic lesions is crucial for proper clinical management. Routine tissue diagnosis with laparotomy or core needle biopsy is seldom performed due to significant morbidity and potential mortality. In addition, core needle biopsy may have potential risk of needle tract tumor implantation. Fine needle aspiration (FNA) has been increasingly used in the diagnosis of pancreatic lesions because of relatively high diagnostic performance and low complication rate [2, 3].
FNA biopsy of pancreatic lesions can be performed via a percutaneous transabdominal or endoscopic approach [3, 4, 5]. Transabdominal biopsy is performed under the guidance of either ultrasound or computed tomography (CT). With the development of linear array echoendoscopy, endoscopic ultrasonography guided FNA (EUS-FNA) has become the choice of diagnostic approach in most institutions [4, 6]. Dependent on the location of the lesion of interest, the biopsy can be performed via a transgastric or transduodenal route. A transduodenal approach is commonly used for the lesions located in the head or uncinate process of the pancreas. If the lesion is located in the body or tail, a transgastric approach is generally used. Recognition of gastric or duodenal epithelial contaminants can be essential to avoid misinterpretation during cytological evaluation of the specimens [7].
Dependent on the nature of pancreatic lesions, different diagnostic approaches may be employed. For solid lesions, a definite diagnosis is highly desirable and can be achieved by cytomorphologic analysis with or without ancillary studies [1, 2, 4, 5, 6, 7]. To render a diagnosis of pancreatic neoplasms other than ductal adenocarcinoma, adjunct ancillary studies including immunocytochemistry may be required [2, 4]. Rapid on-site evaluation during the procedure helps ensure adequate sampling and appropriate specimen triage [8]. In our experience, if there are grossly visible particles in the needle rinse from an FNA pass that shows diagnostic cells on rapid smears, Cellient cell blocks are highly likely to contain diagnostic tissue fragments. If the lesion is cystic, EUS-FNA primarily serves as a tool for risk assessment, identifying the lesions with high grade dysplasia or malignant potential that may require surgical intervention [9, 10, 11]. To achieve this goal, an integrated approach that combines imaging studies, cytomorphologic evaluation, cyst fluid analysis and molecular tests is recommended [11, 12, 13]. For solid pancreatic neoplasms, terminology similar to that used in the histopathology is preferred. For cystic lesions, a descriptive diagnosis may be acceptable.
Ductal adenocarcinoma is the most common malignancy seen in the pancreas, accounting for 75% to 90% of all solid pancreatic masses. Most ductal adenocarcinomas can be diagnosed without difficulty based on cytomorphologic analysis alone. However, well-differentiated adenocarcinoma can impose a diagnostic challenge due to subtle cytologic atypia. There are some cytomorphologic features that may provide a diagnostic clue [1]. The epithelial groups seen in well-differentiated adenocarcinoma are often disorganized and have a drunken honeycomb pattern. In addition, these epithelial cells show variable degrees of anisonucleosis and nuclear membrane irregularity. Nevertheless, well-differentiated adenocarcinoma can still be difficult to diagnosis in some cases. Furthermore, superimposed chronic pancreatitis and pancreatic intraepithelial neoplasia may complicate the diagnosis [14, 15]. A few promising immunohistochemical markers to distinguish chronic pancreatitis from pancreatic adenocarcinoma have begun to emerge [16, 17], and cell blocks provide an ideal platform for immunohistochemistry. Cell block sections may display better tumor cell morphology and diagnostic growth patterns, and they can also demonstrate the relationship of tumor with surrounding tissue [18]. Cell block sections provide a common platform that can be shared with surgical pathologists to allow diagnosis of morphologic variants of pancreatic carcinomas.
Acinar cell carcinoma is a rare malignant tumor which is difficult to diagnose based on cytomorphologic features alone. It must be distinguished from pancreatic endocrine neoplasm as well as benign acinar tissue [1, 19]. Architectural features evident in cell block sections can be very important because the cytologic features may be very bland. Loss of normal acinar structures with the production of aberrant architectures such as solid and trabecular patterns can readily be appreciated on the cellblock sections. Zymogen granules in acinar cell carcinoma can be highlighted by diastase-digested PAS (D-PAS) stain, and trypsin and chymotrypsin immunostains.
Solid pseudo-papillary tumor and pancreatic endocrine neoplasm are two other entities that may present as a solid or partially cystic mass. They have characteristic cytomorphologic features which are well documented in the literature [1, 20, 21, 22, 23]. However, immunocytochemical studies are often performed to confirm the diagnosis. Immunochemically, solid pseudo-papillary tumor is positive for vimentin, beta-catenin, and CD10, and negative for cytokeratin [20, 23, 24]. Diagnosis of pancreatic endocrine neoplasms is supported by immunoreactivity with chromogranin and synaptophysin [2, 21, 22]. Thus, additional material should be saved for cell block preparation if the differential diagnosis includes the entities mentioned above.
Cystic pancreatic lesions include non-neoplastic, benign and malignant neoplasms. Evaluation of cytomorphologic features alone is often insufficient for accurate classification of these lesions. Limiting factors include scant cellularity, overlapping cytomorphologic features, and gastrointestinal contaminants. Incorporation of imaging findings, cyst fluid analysis, and molecular test results with cytological evaluation is highly recommended [11]. Imaging studies define the size, location, and complexity of the lesion and its relationship with the pancreatic duct. Cyst fluid analysis including CEA and amylase levels helps in separating non-neoplastic pancreatic pseudocysts from neoplastic non-mucinous and mucinous cysts [9, 12, 13]. Assessment of malignancy, or risk for malignancy, may benefit from molecular tests such as K-ras mutation analysis and loss of heterozygosity (LOH) of tumor suppressor genes [11, 12, 13].
Among the cystic lesions, intraductal papillary mucinous neoplasm (IPMN) has unique imaging findings and characteristic cytomorphologic features. The presence of papillary fragments, characteristic haphazard mixtures of goblet cells within mucinous epithelium, and a cystic mucinous background with histiocytes helps render the diagnosis of IPMN [25]. However, these cytomorphologic features, particularly true papillary fragments with fibrovascular cores, are uncommonly seen in the aspirates. Further, the distinction between normal gastric, normal small intestinal, and the sometimes minimally atypical epithelium of an IPMN can be difficult on monolayer preparations. Careful examination of cell block material may reveal these histologic diagnostic features. Overall, FNA has shown a relatively low diagnostic rate for IPMN [25, 26]. IPMN is cytologically almost indistinguishable from a mucinous cystic neoplasm [25]; imaging findings usually can make this distinction. Many cytologists lump IMPN and mucinous cystic neoplasms together by simply diagnosing “mucin-producing cystic neoplasm”, with an attempt to characterize whether or not there is evidence of high grade atypia/dysplasia in the sample [27]. Since histology is still considered to be the gold standard for diagnosis of high grade dysplasia [28], cell blocks are particularly valuable for creating a common platform for developing consensus with surgical pathologists on this important diagnosis. Examples are shown. Cyst fluid analysis may have some value in predicting malignancy [29]. Serous cystadenoma can also be diagnosed by cytology and distinguished from mucinous cystic neoplasms [30,31,32].
It is not uncommon for a pancreatic mass to represent a metastasis. These patients may or may not have a documented history of malignancy. The most common carcinomas metastatic to the pancreas are renal cell carcinoma and lung carcinoma [33,34,35]. Malignant mesenchymal neoplasms may also involve the pancreas [36]. These metastatic tumors may display cytomorphologic features that overlap with primary pancreatic neoplasms. Cell block sections provide a better assessment of their morphologic features and can be used for immunocytochemical analysis, which is a crucial component for work-up of the origin and precise diagnosis.
Primary pancreatic lymphomas are rare [37,38,39]. More often, pancreatic lymphomas represent a systemic involvement by lymphoproliferative disorders. Diffuse large B-cell lymphoma and plasma cell neoplasm are probably the two most common lymphoproliferative disorders involving the pancreas. Although these lymphoproliferative disorders may have unique cytomorphologic features, ancillary immunophenotyping studies such as flow cytometry or/and immunocytochemistry are required for the diagnosis. It is crucial to recognize these lymphoid lesions during the on-site evaluation. Part of the aspirates should be saved for flow cytometry as well as processed for cell block preparation. Cell block preparation serves for both morphologic evaluation and potential immunocytochemical studies.
In this chapter, we will illustrate the benefits of combinational cytology and cell block preparations to improve FNA diagnosis of pancreatic lesions.
for an enlarged view.
Benign

Benign pancreatic ductal cells,
Pancreas FNA, Direct Smear.
Normal pancreatic ductal cells are small and uniform, forming a cohesive monolayer sheet.
40X
Benign pancreatic ductal cells,
Pancreas FNA, Direct Smear.
Normal pancreatic ductal cells are small and uniform, forming a cohesive monolayer sheet.
40X

Benign pancreatic acini,
Pancreas FNA, Cell Block.
Normal pancreatic acinar cells are small and have granular cytoplasm, arranged in an acinar pattern.
40X
Benign pancreatic acini,
Pancreas FNA, Cell Block.
Normal pancreatic acinar cells are small and have granular cytoplasm, arranged in an acinar pattern.
40X

Benign pancreatic acini and islet cells,
Pancreas FNA, Cell Block.
Fragment of normal pancreatic tissue shows acinar cells with granular cytoplasm arranged in an acinar pattern. In the center of the fragment is an islet composed of small epithelioid cells with delicate non-granular cytoplasm.
20X
Benign pancreatic acini and islet cells,
Pancreas FNA, Cell Block.
Fragment of normal pancreatic tissue shows acinar cells with granular cytoplasm arranged in an acinar pattern. In the center of the fragment is an islet composed of small epithelioid cells with delicate non-granular cytoplasm.
20X

Benign duodenal epithelial cells,
Pancreas FNA, ThinPrep.
Normal duodenal epithelial cells form large cohesive clusters with prominent papillary projections. Within the projections, there are scattered cells with large intracytoplasmic vacuoles and eccentrically located nuclei, which represent goblet cells. Fragments of benign duodenal epithelium can be seen as contaminants during trans-duodenal FNA of pancreatic lesions. (Courtesy of Dr. Andrew Fischer)
40X
Benign duodenal epithelial cells,
Pancreas FNA, ThinPrep.
Normal duodenal epithelial cells form large cohesive clusters with prominent papillary projections. Within the projections, there are scattered cells with large intracytoplasmic vacuoles and eccentrically located nuclei, which represent goblet cells. Fragments of benign duodenal epithelium can be seen as contaminants during trans-duodenal FNA of pancreatic lesions. (Courtesy of Dr. Andrew Fischer)
40X

Benign gastric epithelial cells,
Pancreas FNA, Direct Smear.
Normal gastric epithelial cells form a large cohesive sheet. The epithelial cells are small and uniform, arranged in an orderly fashion. Gastric contaminants can be seen during trans-gastric FNA of pancreatic lesions. It can be difficult or impossible to distinguish gastric mucosal cells from either benign biliary epithelium or low-grade mucinous cystic neoplastic epithelium on direct smears.
10X
Benign gastric epithelial cells,
Pancreas FNA, Direct Smear.
Normal gastric epithelial cells form a large cohesive sheet. The epithelial cells are small and uniform, arranged in an orderly fashion. Gastric contaminants can be seen during trans-gastric FNA of pancreatic lesions. It can be difficult or impossible to distinguish gastric mucosal cells from either benign biliary epithelium or low-grade mucinous cystic neoplastic epithelium on direct smears.
10X

Benign gastric epithelial cells,
Pancreas FNA, Cell Block.
Normal gastric foveolar epithelial cells form large glands. The epithelial cells are columnar and contain apical intracytoplasmic mucin. Note the regular basal positioning of the nuclei and the absence of goblet cells and fibrovascular cores. Gastric contaminants can be encountered during trans-gastric FNA of pancreatic lesions.
20X
Benign gastric epithelial cells,
Pancreas FNA, Cell Block.
Normal gastric foveolar epithelial cells form large glands. The epithelial cells are columnar and contain apical intracytoplasmic mucin. Note the regular basal positioning of the nuclei and the absence of goblet cells and fibrovascular cores. Gastric contaminants can be encountered during trans-gastric FNA of pancreatic lesions.
20X

Glandular epithelial cells of uncertain origin, Pancreas FNA, Direct Smear.
The differential diagnosis for a cluster such as this is benign gastric foveolar epithelium and epithelium from a mucin-producing cystic neoplasm. In favor of the latter is that the nuclear spacing is slightly irregular and focal areas suggest some stratification of the cells into slender micropapillary projections. There are no goblet cells to suggest that this is duodenal mucosa. Knowledge of whether the FNA is trans-gastric or trans-duodenal and whether the lesion is cystic can be helpful for interpretation. Cell blocks can also help to demonstrate true stratification which would be consistent with neoplastic epithelium.
20X
Glandular epithelial cells of uncertain origin, Pancreas FNA, Direct Smear.
The differential diagnosis for a cluster such as this is benign gastric foveolar epithelium and epithelium from a mucin-producing cystic neoplasm. In favor of the latter is that the nuclear spacing is slightly irregular and focal areas suggest some stratification of the cells into slender micropapillary projections. There are no goblet cells to suggest that this is duodenal mucosa. Knowledge of whether the FNA is trans-gastric or trans-duodenal and whether the lesion is cystic can be helpful for interpretation. Cell blocks can also help to demonstrate true stratification which would be consistent with neoplastic epithelium.
20X

Benign duodenal epithelial cells,
Pancreas FNA, Cell Block.
Normal duodenal epithelial cells show a mixture of goblet cells (one is shown with the long arrow) and absorptive cells. The absorptive cells have an eosinophilic cytoplasm without mucous, and they have a brush border on the apical side (short arrows). A brush border is often easier to see in histologic sections compared to smears. The presence of a brush border essentially rules out the possibility of a neoplastic process since mucin-producing cystic neoplasms do not show a brush border. Duodenal contaminants are common in FNA of lesions of the pancreatic head. (Courtesy of Dr. Andrew Fischer)
60X
Benign duodenal epithelial cells,
Pancreas FNA, Cell Block.
Normal duodenal epithelial cells show a mixture of goblet cells (one is shown with the long arrow) and absorptive cells. The absorptive cells have an eosinophilic cytoplasm without mucous, and they have a brush border on the apical side (short arrows). A brush border is often easier to see in histologic sections compared to smears. The presence of a brush border essentially rules out the possibility of a neoplastic process since mucin-producing cystic neoplasms do not show a brush border. Duodenal contaminants are common in FNA of lesions of the pancreatic head. (Courtesy of Dr. Andrew Fischer)
60X

Chronic pancreatitis, Pancreas FNA, Cell Block
Benign pancreatic acinar cells are intermixed with fragments of fibrous tissue and lymphoplasmacytic infiltrates. The acinar cells are small and arranged in an acinar pattern. Note relatively preserved lobular appearance of pancreatic acini.
20X
Chronic pancreatitis,
Pancreas FNA, Cell Block
Benign pancreatic acinar cells are intermixed with fragments of fibrous tissue and lymphoplasmacytic infiltrates. The acinar cells are small and arranged in an acinar pattern. Note relatively preserved lobular appearance of pancreatic acini.
20X
Ductal Adenocarcinoma

Ductal adenocarcinoma #1,
Pancreas FNA, Direct Smear.
The aspirates show single and clusters of malignant epithelial cells. The clusters are three-dimensional with overlapped nuclei. A few histiocytes are seen in the background.
20X
Ductal adenocarcinoma #1,
Pancreas FNA, Direct Smear.
The aspirates show single and clusters of malignant epithelial cells. The clusters are three-dimensional with overlapped nuclei. A few histiocytes are seen in the background.
20X

Ductal adenocarcinoma #1,
Pancreas FNA, Direct Smear.
At a higher magnification, the tumor cells are large and pleomorphic and have an unpredictable orientation to each other.
40X
Ductal adenocarcinoma #1,
Pancreas FNA, Direct Smear.
At a higher magnification, the tumor cells are large and pleomorphic and have an unpredictable orientation to each other.
40X

Ductal adenocarcinoma #1,
Pancreas FNA, Direct Smear.
The tumor cells have prominent intracytoplasmic vacuoles, irregular nuclear contours, vesicular chromatin and are arranged in three-dimensional clusters.
40X
Ductal adenocarcinoma #1,
Pancreas FNA, Direct Smear.
The tumor cells have prominent intracytoplasmic vacuoles, irregular nuclear contours, vesicular chromatin and are arranged in three-dimensional clusters.
40X

Ductal adenocarcinoma #1,
Pancreas FNA, Cell Block.
The tumor cells are pleomorphic and form poorly organized glands of variable sizes. Some of the glands are fused together. Prominent intracytoplasmic mucin is present.
40X
Ductal adenocarcinoma #1,
Pancreas FNA, Cell Block.
The tumor cells are pleomorphic and form poorly organized glands of variable sizes. Some of the glands are fused together. Prominent intracytoplasmic mucin is present.
40X

Ductal adenocarcinoma #2,
Pancreas FNA, Direct Smear.
The aspirates show single and clusters of malignant epithelial cells with unpredictable nuclear to cytoplasmic ratios. Metachromatic extracellular mucinous material is readily seen in the background as well as intermixed with epithelial cell clusters.
10X
Ductal adenocarcinoma #2,
Pancreas FNA, Direct Smear.
The aspirates show single and clusters of malignant epithelial cells with unpredictable nuclear to cytoplasmic ratios. Metachromatic extracellular mucinous material is readily seen in the background as well as intermixed with epithelial cell clusters.
10X

Ductal adenocarcinoma #2,
Pancreas FNA, Direct Smear.
The tumor cells are large and pleomorphic and present as single cells and three-dimensional clusters. Overlapping nuclei are seen within the clusters.
20X
Ductal adenocarcinoma #2,
Pancreas FNA, Direct Smear.
The tumor cells are large and pleomorphic and present as single cells and three-dimensional clusters. Overlapping nuclei are seen within the clusters.
20X

Ductal adenocarcinoma #2,
Pancreas FNA, Direct Smear.
At a higher magnification, the tumor cells show irregular nuclear contours and occasional intracytoplasmic vacuoles. Note the presence of extracellular mucin-like material adjacent to the epithelial cluster.
40X
Ductal adenocarcinoma #2,
Pancreas FNA, Direct Smear.
At a higher magnification, the tumor cells show irregular nuclear contours and occasional intracytoplasmic vacuoles. Note the presence of extracellular mucin-like material adjacent to the epithelial cluster.
40X

Ductal adenocarcinoma #2,
Pancreas FNA, Cell Block.
The tumor cells are large, columnar and form glandular structures. Focal stratification is seen with fused glands. Intracytoplasmic mucin is present in some of tumor cells.
40X
Ductal adenocarcinoma #2,
Pancreas FNA, Cell Block.
The tumor cells are large, columnar and form glandular structures. Focal stratification is seen with fused glands. Intracytoplasmic mucin is present in some of tumor cells.
40X

Ductal adenocarcinoma #3,
Pancreas FNA, Direct Smear.
The aspirates show clusters of malignant epithelial cells in a background of abundant mucin-like material. A few single tumor cells are also present. Present also are two clusters of benign gastrointestinal contaminants (center and right edge).
10X
Ductal adenocarcinoma #3,
Pancreas FNA, Direct Smear.
The aspirates show clusters of malignant epithelial cells in a background of abundant mucin-like material. A few single tumor cells are also present. Present also are two clusters of benign gastrointestinal contaminants (center and right edge).
10X

Ductal adenocarcinoma #3,
Pancreas FNA, Direct Smear.
At a higher magnification, the tumor cells are haphazardly arranged with stratification and they show intracytoplasmic vacuoles, irregular nuclear contours, vesicular chromatin and small nucleoli.
40X
Ductal adenocarcinoma #3,
Pancreas FNA, Direct Smear.
At a higher magnification, the tumor cells are haphazardly arranged with stratification and they show intracytoplasmic vacuoles, irregular nuclear contours, vesicular chromatin and small nucleoli.
40X

Ductal adenocarcinoma #3,
Pancreas FNA, Cell Block.
The tumor cells form glandular structures with focal loss of cell polarity and stratification. There are also scattered single and small groups of tumor cells. Intracytoplasmic mucin is seen in some of the tumor cells. Note extracellular mucin (right edge) and a background of necrotic cellular debris.
40X
Ductal adenocarcinoma #3,
Pancreas FNA, Cell Block.
The tumor cells form glandular structures with focal loss of cell polarity and stratification. There are also scattered single and small groups of tumor cells. Intracytoplasmic mucin is seen in some of the tumor cells. Note extracellular mucin (right edge) and a background of necrotic cellular debris.
40X

Ductal adenocarcinoma #4,
Pancreas FNA, Direct Smear.
The aspirate shows a cluster of malignant epithelial cells with probable cribriform configuration. Necrotic cellular debris is present in the background.
20X
Ductal adenocarcinoma #4,
Pancreas FNA, Direct Smear.
The aspirate shows a cluster of malignant epithelial cells with probable cribriform configuration. Necrotic cellular debris is present in the background.
20X

Ductal adenocarcinoma #4,
Pancreas FNA, Direct Smear.
The tumor cells are relatively uniform and present as a large three-dimensional cluster. A diagnostic stratified (three-dimensional) growth pattern can be seen focally.
20X
Ductal adenocarcinoma #4,
Pancreas FNA, Direct Smear.
The tumor cells are relatively uniform and present as a large three-dimensional cluster. A diagnostic stratified (three-dimensional) growth pattern can be seen focally.
20X

Ductal adenocarcinoma #4,
Pancreas FNA, Cell Block.
A definite cribriform architecture is easier to appreciate in the cell block section. True cribriform patterns such as this are a key diagnostic feature of at least high grade dysplasia. Necrosis and sufficient nuclear variation are present to justify a diagnosis of adenocarcinoma.
20X
Ductal adenocarcinoma #4,
Pancreas FNA, Cell Block.
A definite cribriform architecture is easier to appreciate in the cell block section. True cribriform patterns such as this are a key diagnostic feature of at least high grade dysplasia. Necrosis and sufficient nuclear variation are present to justify a diagnosis of adenocarcinoma.
20X

Ductal adenocarcinoma #4,
Pancreas FNA, Cell Block.
At a higher magnification, the tumor cells show a disordered arrangement with variable degrees of hyperchromasia (predictive of aneuploidy). A mitosis is seen in the one of tumor cells.
40X
Ductal adenocarcinoma #4,
Pancreas FNA, Cell Block.
At a higher magnification, the tumor cells show a disordered arrangement with variable degrees of hyperchromasia (predictive of aneuploidy). A mitosis is seen in the one of tumor cells.
40X

Ductal adenocarcinoma #5,
Pancreas FNA, Direct Smear.
The aspirates show clusters of malignant epithelial cells intermixed with fibrous tissue fragments.
20X
Ductal adenocarcinoma #5,
Pancreas FNA, Direct Smear.
The aspirates show clusters of malignant epithelial cells intermixed with fibrous tissue fragments.
20X

Ductal adenocarcinoma #5,
Pancreas FNA, Direct Smear.
Clusters of tumor cells are intermixed with fibrous tissue fragments. The tumor shows a three-dimensional growth pattern with irregular spacing of nuclei, diagnostic of carcinoma.
20X
Ductal adenocarcinoma #5,
Pancreas FNA, Direct Smear.
Clusters of tumor cells are intermixed with fibrous tissue fragments. The tumor shows a three-dimensional growth pattern with irregular spacing of nuclei, diagnostic of carcinoma.
20X

Ductal adenocarcinoma #5,
Pancreas FNA, Cell Block.
The cell block shows unequivocal invasion of the fibrous tissue by the malignant cells. Invasive foci such as this are difficult or impossible to diagnose without a cell block section.
20X
Ductal adenocarcinoma #5,
Pancreas FNA, Cell Block.
The cell block shows unequivocal invasion of the fibrous tissue by the malignant cells. Invasive foci such as this are difficult or impossible to diagnose without a cell block section.
20X
Adenocarcinoma with Mucinous Features

At least high grade dysplasia in a mucin-producing cystic neoplasm,
Pancreas FNA, Direct Smear.
The aspirates show single and small clusters of relatively uniform epithelial cells with intracytoplasmic mucin. Extracellular mucin is also seen in the background. The differential diagnosis for a field such as this could include an intraductal papillary mucinous neoplasm (IPMN). There is probable randomization of polarity of adjacent cells, a feature that would support a diagnosis of at least high grade dysplasia in a mucin-producing cystic neoplasm.
20X
At least high grade dysplasia in a mucin-producing cystic neoplasm,
Pancreas FNA, Direct Smear.
The aspirates show single and small clusters of relatively uniform epithelial cells with intracytoplasmic mucin. Extracellular mucin is also seen in the background. The differential diagnosis for a field such as this could include an intraductal papillary mucinous neoplasm (IPMN). There is probable randomization of polarity of adjacent cells, a feature that would support a diagnosis of at least high grade dysplasia in a mucin-producing cystic neoplasm.
20X

Adenocarcinoma with mucinous features,
Pancreas FNA, Direct Smear.
At a higher magnification of the same case as shown in Figure 28, the tumor cells show more pronounced loss of polarity, with a greater degree of nuclear variation (predictive of aneuploidy), justifying a diagnosis of at least high grade dysplasia in a mucin-producing cystic neoplasm or adenocarcinoma with mucinous features.
40X
Adenocarcinoma with mucinous features,
Pancreas FNA, Direct Smear.
At a higher magnification of the same case as shown in Figure 28, the tumor cells show more pronounced loss of polarity, with a greater degree of nuclear variation (predictive of aneuploidy), justifying a diagnosis of at least high grade dysplasia in a mucin-producing cystic neoplasm or adenocarcinoma with mucinous features.
40X

Neoplastic mucinous epithelium,
Pancreas FNA, Cell Block.
The tumor cells form large glands, which have a “hyperplastic” appearance. These larger glands may represent low grade dysplasia in a mucin-producing cystic neoplasm. There are also a few small glands with nuclear variation and loss of polarity, features that suggest the diagnosis of high grade dysplasia.
20X
Neoplastic mucinous epithelium,
Pancreas FNA, Cell Block.
The tumor cells form large glands, which have a “hyperplastic” appearance. These larger glands may represent low grade dysplasia in a mucin-producing cystic neoplasm. There are also a few small glands with nuclear variation and loss of polarity, features that suggest the diagnosis of high grade dysplasia.
20X

Neoplastic mucinous epithelium,
Pancreas FNA, Cell Block.
At a higher magnification of the group in Figure 30, the tumor cells that form “hyperplastic” glands are intensely crowded, with abundant intracytoplasmic mucin, but they are mostly still growing in a two-dimensional arrangement. The smaller detached clusters show more prominent nuclear variation and some loss of polarity compatible with high grade dysplasia.
40X
Neoplastic mucinous epithelium,
Pancreas FNA, Cell Block.
At a higher magnification of the group in Figure 30, the tumor cells that form “hyperplastic” glands are intensely crowded, with abundant intracytoplasmic mucin, but they are mostly still growing in a two-dimensional arrangement. The smaller detached clusters show more prominent nuclear variation and some loss of polarity compatible with high grade dysplasia.
40X
Poorly Differentiated Adenocarcinoma

Adenocarcinoma, poorly differentiated,
Pancreas FNA, Direct Smear.
The aspirates show single and clusters of malignant epithelial cells with large pleomorphic nuclei growing in a three-dimensional arrangement. Scattered small lymphocytes are seen in the background.
20X
Adenocarcinoma, poorly differentiated,
Pancreas FNA, Direct Smear.
The aspirates show single and clusters of malignant epithelial cells with large pleomorphic nuclei growing in a three-dimensional arrangement. Scattered small lymphocytes are seen in the background.
20X

Adenocarcinoma, poorly differentiated,
Pancreas FNA, Direct Smear.
The tumor cells are large, pleomorphic and have vacuolated cytoplasm and hyperchromatic nuclei.
40X
Adenocarcinoma, poorly differentiated,
Pancreas FNA, Direct Smear.
The tumor cells are large, pleomorphic and have vacuolated cytoplasm and hyperchromatic nuclei.
40X

Adenocarcinoma, poorly differentiated,
Pancreas FNA, Direct Smear.
The tumor cells seen in this cluster are large and have enlarged nuclei with irregular nuclear contours and variably enlarged nucleoli.
40X
Adenocarcinoma, poorly differentiated,
Pancreas FNA, Direct Smear.
The tumor cells seen in this cluster are large and have enlarged nuclei with irregular nuclear contours and variably enlarged nucleoli.
40X

Adenocarcinoma, poorly differentiated,
Pancreas FNA, Cell Block.
Large pleomorphic tumor cells are present singly or in small stratified groups with irregular glandular lumina. Necrosis is present.
40X
Adenocarcinoma, poorly differentiated,
Pancreas FNA, Cell Block.
Large pleomorphic tumor cells are present singly or in small stratified groups with irregular glandular lumina. Necrosis is present.
40X
Adenosquamous Carcinoma

Adenosquamous carcinoma,
Pancreas FNA, Cell Block.
The cell block sections show the tumor cells with two divergent morphologic features. In this field, tumor cells contain mucin and form glands. See next image for a separate population of tumor cells with squamous differentiation.
10X
Adenosquamous carcinoma,
Pancreas FNA, Cell Block.
The cell block sections show the tumor cells with two divergent morphologic features. In this field, tumor cells contain mucin and form glands. See next image for a separate population of tumor cells with squamous differentiation.
10X

Adenosquamous carcinoma,
Pancreas FNA, Cell Block.
(Same case as in Figure 36) The tumor cells in the squamous component show distinct cell borders with intercellular bridges. Individual cell necrosis is seen within the sheet. Cellular necrosis is also present in the background.
40X
Adenosquamous carcinoma,
Pancreas FNA, Cell Block.
(Same case as in Figure 36) The tumor cells in the squamous component show distinct cell borders with intercellular bridges. Individual cell necrosis is seen within the sheet. Cellular necrosis is also present in the background.
40X
Undifferentiated Anaplastic Carcinoma

Undifferentiated anaplastic carcinoma,
Pancreas FNA, Direct Smear.
The aspirates show predominantly single malignant cells. The tumor cells are extremely large and pleomorphic. Abundant inflammatory cells are seen in the background.
20X
Undifferentiated anaplastic carcinoma,
Pancreas FNA, Direct Smear.
The aspirates show predominantly single malignant cells. The tumor cells are extremely large and pleomorphic. Abundant inflammatory cells are seen in the background.
20X

Undifferentiated anaplastic carcinoma,
Pancreas FNA, Direct Smear.
At a higher magnification, the tumor cells are extremely large and pleomorphic. Multinucleated tumor giant cells are frequently seen. The background inflammatory infiltrates are predominantly neutrophils.
40X
Undifferentiated anaplastic carcinoma,
Pancreas FNA, Direct Smear.
At a higher magnification, the tumor cells are extremely large and pleomorphic. Multinucleated tumor giant cells are frequently seen. The background inflammatory infiltrates are predominantly neutrophils.
40X

Undifferentiated anaplastic carcinoma,
Pancreas FNA, Direct Smear.
The tumor cells, mono-, bi- or multinucleated, have irregular nuclear contours and prominent nucleoli. Abundant neutrophils are seen in the background. Immunohistochemical studies may be needed in a case such as this to exclude a metastatic lesion such as metastatic melanoma, or even a sarcoma.
40X
Undifferentiated anaplastic carcinoma,
Pancreas FNA, Direct Smear.
The tumor cells, mono-, bi- or multinucleated, have irregular nuclear contours and prominent nucleoli. Abundant neutrophils are seen in the background. Immunohistochemical studies may be needed in a case such as this to exclude a metastatic lesion such as metastatic melanoma, or even a sarcoma.
40X

Undifferentiated anaplastic carcinoma,
Pancreas FNA, Cell Block.
Large pleomorphic tumor cells are present singly. Bi- and multinucleation is frequently seen. An atypical mitosis is identified in one of the tumor cells (right upper). Abundant neutrophils are seen in the background.
40X
Undifferentiated anaplastic carcinoma,
Pancreas FNA, Cell Block.
Large pleomorphic tumor cells are present singly. Bi- and multinucleation is frequently seen. An atypical mitosis is identified in one of the tumor cells (right upper). Abundant neutrophils are seen in the background.
40X

Undifferentiated anaplastic carcinoma,
Pancreas FNA, Cell Block.
The tumor cells are strongly positive for vimentin. The finding raises the possibility of a sarcoma or melanoma, but does not exclude the possibility of a carcinoma.
40X
Undifferentiated anaplastic carcinoma,
Pancreas FNA, Cell Block.
The tumor cells are strongly positive for vimentin. The finding raises the possibility of a sarcoma or melanoma, but does not exclude the possibility of a carcinoma.
40X

Undifferentiated anaplastic carcinoma,
Pancreas FNA, Cell Block.
The tumor cells are immunoreactive with cytokeratin stain. Here, CK7 stain is positive in tumor cells, confirming a diagnosis of carcinoma.
40X
Undifferentiated anaplastic carcinoma,
Pancreas FNA, Cell Block.
The tumor cells are immunoreactive with cytokeratin stain. Here, CK7 stain is positive in tumor cells, confirming a diagnosis of carcinoma.
40X
Small Cell Carcinoma

Small cell carcinoma,
Pancreas FNA, Direct Smear.
The aspirates show single and dyshesive clusters of malignant epithelial cells. The tumor cells are intermediate in size and have high nuclear to cytoplasmic ratios. Abundant necrosis is seen. Smear crush artifact (nuclear streaming) is focally seen.
40X
Small cell carcinoma,
Pancreas FNA, Direct Smear.
The aspirates show single and dyshesive clusters of malignant epithelial cells. The tumor cells are intermediate in size and have high nuclear to cytoplasmic ratios. Abundant necrosis is seen. Smear crush artifact (nuclear streaming) is focally seen.
40X

Small cell carcinoma,
Pancreas FNA, Direct Smear.
The tumor cells have speckled (“salt and pepper”) chromatin and inconspicuous nucleoli with some nuclear molding. Necrosis is readily seen. The features suggest a high grade small cell neuroendocrine carcinoma. Small cell carcinomas may be primary or metastatic to the pancreas and they may need to be distinguished from other “small blue cell tumors”. Immunohistochemical studies are useful to confirm neuroendocrine differentiation and to help exclude other forms of small blue cell tumors.
40X
Small cell carcinoma,
Pancreas FNA, Direct Smear.
The tumor cells have speckled (“salt and pepper”) chromatin and inconspicuous nucleoli with some nuclear molding. Necrosis is readily seen. The features suggest a high grade small cell neuroendocrine carcinoma. Small cell carcinomas may be primary or metastatic to the pancreas and they may need to be distinguished from other “small blue cell tumors”. Immunohistochemical studies are useful to confirm neuroendocrine differentiation and to help exclude other forms of small blue cell tumors.
40X

Small cell carcinoma,
Pancreas FNA, Cell Block.
The tumor cells with high nuclear to cytoplasmic ratios are present singly and in loose groups. Necrosis is present.
20X
Small cell carcinoma,
Pancreas FNA, Cell Block.
The tumor cells with high nuclear to cytoplasmic ratios are present singly and in loose groups. Necrosis is present.
20X

Small cell carcinoma,
Pancreas FNA, Cell Block.
The tumor cells are immunoreactive with neuroendocrine markers, chromogranin, synaptophysin or CD56. Shown is a synaptophysin stain, which is positive in tumor cells. It is important to note that small cell carcinomas of pancreatic origin may be positive for the pulmonary marker TTF-1. Clinical correlation is required to rule out a lung metastasis if TTF-1 is positive.
20X
Small cell carcinoma,
Pancreas FNA, Cell Block.
The tumor cells are immunoreactive with neuroendocrine markers, chromogranin, synaptophysin or CD56. Shown is a synaptophysin stain, which is positive in tumor cells. It is important to note that small cell carcinomas of pancreatic origin may be positive for the pulmonary marker TTF-1. Clinical correlation is required to rule out a lung metastasis if TTF-1 is positive.
20X
Squamous Cell Carcinoma

Squamous cell carcinoma,
Pancreas FNA, Cell Block.
The cell block sections show single and sheets of malignant epithelial cells in a background of necrosis. Since pure squamous cell carcinoma is rare in the pancreas, ample sampling is recommended to search for the presence of another component such as adenocarcinoma. Clinical correlation is required to distinguish between a pure squamous cell carcinoma of the pancreas from a metastasis from other sites such as lung. (Courtesy of Dr. Andrew Fischer)
10X
Squamous cell carcinoma,
Pancreas FNA, Cell Block.
The cell block sections show single and sheets of malignant epithelial cells in a background of necrosis. Since pure squamous cell carcinoma is rare in the pancreas, ample sampling is recommended to search for the presence of another component such as adenocarcinoma. Clinical correlation is required to distinguish between a pure squamous cell carcinoma of the pancreas from a metastasis from other sites such as lung. (Courtesy of Dr. Andrew Fischer)
10X

Squamous cell carcinoma,
Pancreas FNA, Cell Block.
The tumor cells are pleomorphic, have dense cytoplasm and focally form squamous “pearls” (keratinization).
40X
Squamous cell carcinoma,
Pancreas FNA, Cell Block.
The tumor cells are pleomorphic, have dense cytoplasm and focally form squamous “pearls” (keratinization).
40X
Squamous cell carcinoma,
Pancreas FNA, Cell Block.
At a higher magnification, intercellular bridges are seen in the sheets of tumor cells.
60X
Squamous cell carcinoma,
Pancreas FNA, Cell Block.
At a higher magnification, intercellular bridges are seen in the sheets of tumor cells.
60X
Acinar Cell Carcinoma

Acinar cell carcinoma,
Pancreas FNA, ThinPrep.
The aspirates show clusters of dyshesive malignant epithelial cells. The tumor cells are relatively uniform and do not show a normal acinar cell arrangement. The differential diagnosis could include a low grade neuroendocrine neoplasm. A few flecks of black metal is present, a common contaminant in endoscopic FNA samples. (Courtesy of Dr. Andrew Fischer)
40X
Acinar cell carcinoma,
Pancreas FNA, ThinPrep.
The aspirates show clusters of dyshesive malignant epithelial cells. The tumor cells are relatively uniform and do not show a normal acinar cell arrangement. The differential diagnosis could include a low grade neuroendocrine neoplasm. A few flecks of black metal is present, a common contaminant in endoscopic FNA samples. (Courtesy of Dr. Andrew Fischer)
40X

Acinar cell carcinoma,
Pancreas FNA, ThinPrep.
The tumor cells are not arranged in a normal tight acinar grouping. They show a mild variation in size and have round nuclei with slight nuclear membrane irregularity and small nucleoli. Note the presence of some dead cells in the lower portion within the cluster.
60X
Acinar cell carcinoma,
Pancreas FNA, ThinPrep.
The tumor cells are not arranged in a normal tight acinar grouping. They show a mild variation in size and have round nuclei with slight nuclear membrane irregularity and small nucleoli. Note the presence of some dead cells in the lower portion within the cluster.
60X

Acinar cell carcinoma,
Pancreas FNA, Cell Block.
The tumor cells form a prominent cribriform growth pattern with a deceptively bland and uniform appearance. A prominent cribriform pattern would be unusual for a low grade neuroendocrine neoplasm but immunohistochemistry is required to make the distinction. (Courtesy of Dr. Andrew Fischer)
10X
Acinar cell carcinoma,
Pancreas FNA, Cell Block.
The tumor cells form a prominent cribriform growth pattern with a deceptively bland and uniform appearance. A prominent cribriform pattern would be unusual for a low grade neuroendocrine neoplasm but immunohistochemistry is required to make the distinction. (Courtesy of Dr. Andrew Fischer)
10X

Acinar cell carcinoma,
Pancreas FNA, Cell Block.
The tumor cells are enlarged and show only mild pleomorphism with a prominent cribriform growth pattern. Slightly granular dark cytoplasm may be encountered in both acinar cell carcinoma and low grade neuroendocrine neoplasms.
40X
Acinar cell carcinoma,
Pancreas FNA, Cell Block.
The tumor cells are enlarged and show only mild pleomorphism with a prominent cribriform growth pattern. Slightly granular dark cytoplasm may be encountered in both acinar cell carcinoma and low grade neuroendocrine neoplasms.
40X

Acinar cell carcinoma,
Pancreas FNA, Cell Block.
The tumor cells with cribriform growth pattern show focal necrosis and slightly greater nuclear variability.
40X
Acinar cell carcinoma,
Pancreas FNA, Cell Block.
The tumor cells with cribriform growth pattern show focal necrosis and slightly greater nuclear variability.
40X

Acinar cell carcinoma,
Pancreas FNA, Cell Block.
The tumor cells are focally positive for chymotrypsin.
40X
Acinar cell carcinoma,
Pancreas FNA, Cell Block.
The tumor cells are focally positive for chymotrypsin.
40X

Acinar cell carcinoma,
Pancreas FNA, Cell Block.
The tumor cells are also focally positive for trypsin. Negative staining is found for neuroendocrine markers CD56, synaptophysin, and chromogranin, excluding the diagnosis of a pancreatic endocrine neoplasm. Despite the relatively bland appearance and the close resemblance to pancreatic endocrine neoplasms, acinar cell carcinomas are relatively aggressive tumors.
40X
Acinar cell carcinoma,
Pancreas FNA, Cell Block.
The tumor cells are also focally positive for trypsin. Negative staining is found for neuroendocrine markers CD56, synaptophysin, and chromogranin, excluding the diagnosis of a pancreatic endocrine neoplasm. Despite the relatively bland appearance and the close resemblance to pancreatic endocrine neoplasms, acinar cell carcinomas are relatively aggressive tumors.
40X
Pancreatic Endocrine Neoplasm

Pancreatic endocrine neoplasm #1,
Pancreas FNA, Direct Smear.
The aspirates show single and dyshesive clusters of neoplastic cells. The neoplastic cells show mild variation in size and have eccentrically located oval nuclei (plasmacytoid appearance). A few small cytoplasmic vacuoles are seen.
40X
Pancreatic endocrine neoplasm #1,
Pancreas FNA, Direct Smear.
The aspirates show single and dyshesive clusters of neoplastic cells. The neoplastic cells show mild variation in size and have eccentrically located oval nuclei (plasmacytoid appearance). A few small cytoplasmic vacuoles are seen.
40X

Pancreatic endocrine neoplasm #1,
Pancreas FNA, Direct Smear.
Dispersed dyshesive neoplastic cells have speckled (“salt and pepper”) chromatin and inconspicuous nucleoli.
40X
Pancreatic endocrine neoplasm #1,
Pancreas FNA, Direct Smear.
Dispersed dyshesive neoplastic cells have speckled (“salt and pepper”) chromatin and inconspicuous nucleoli.
40X

Pancreatic endocrine neoplasm #1,
Pancreas FNA, Cell Block.
The tumor cells are present singly or in sheets and groups without a crisp, normal acinar arrangement.
40X
Pancreatic endocrine neoplasm #1,
Pancreas FNA, Cell Block.
The tumor cells are present singly or in sheets and groups without a crisp, normal acinar arrangement.
40X

Pancreatic endocrine neoplasm #1,
Pancreas FNA, Cell Block.
The synaptophysin immunostain shows cytoplasmic positivity in the tumor cells, indicative of neuroendocrine differentiation.
40X
Pancreatic endocrine neoplasm #1,
Pancreas FNA, Cell Block.
The synaptophysin immunostain shows cytoplasmic positivity in the tumor cells, indicative of neuroendocrine differentiation.
40X

Pancreatic endocrine neoplasm #1,
Pancreas FNA, Cell Block.
The tumor cells are also positive for chromogranin, another neuroendocrine marker, with a granular cytoplasmic staining pattern.
40X
Pancreatic endocrine neoplasm #1,
Pancreas FNA, Cell Block.
The tumor cells are also positive for chromogranin, another neuroendocrine marker, with a granular cytoplasmic staining pattern.
40X

Pancreatic endocrine neoplasm #2,
Pancreas FNA, Direct Smear.
The aspirates show a cluster of neoplastic epithelial cells with eccentrically located nuclei.
40X
Pancreatic endocrine neoplasm #2,
Pancreas FNA, Direct Smear.
The aspirates show a cluster of neoplastic epithelial cells with eccentrically located nuclei.
40X

Pancreatic endocrine neoplasm #2,
Pancreas FNA, Direct Smear.
The tumor cells are also present singly and have speckled (“salt and pepper”) chromatin and inconspicuous nucleoli. A cluster of benign gastrointestinal contaminants is seen (right lower).
40X
Pancreatic endocrine neoplasm #2,
Pancreas FNA, Direct Smear.
The tumor cells are also present singly and have speckled (“salt and pepper”) chromatin and inconspicuous nucleoli. A cluster of benign gastrointestinal contaminants is seen (right lower).
40X

Pancreatic endocrine neoplasm #2,
Pancreas FNA, Cell Block.
Single and groups of tumor cells with eccentrically located nuclei are present. A solid or vaguely palisaded growth pattern is seen.
40X
Pancreatic endocrine neoplasm #2,
Pancreas FNA, Cell Block.
Single and groups of tumor cells with eccentrically located nuclei are present. A solid or vaguely palisaded growth pattern is seen.
40X

Pancreatic endocrine neoplasm #2,
Pancreas FNA, Cell Block.
The tumor cells show cytoplasmic staining for synaptophysin, supportive of neuroendocrine differentiation.
40X
Pancreatic endocrine neoplasm #2,
Pancreas FNA, Cell Block.
The tumor cells show cytoplasmic staining for synaptophysin, supportive of neuroendocrine differentiation.
40X

Pancreatic endocrine neoplasm #2,
Pancreas FNA, Cell Block.
The tumor cells are also positive for chromogranin (granular cytoplasmic staining).
40X
Pancreatic endocrine neoplasm #2,
Pancreas FNA, Cell Block.
The tumor cells are also positive for chromogranin (granular cytoplasmic staining).
40X
Pseudopapillary Tumor

Solid pseudopapillary tumor,
Pancreas FNA, Direct Smear.
The aspirates show neoplastic epithelioid cells clinging to the branching capillary vasculatures as well as dispersed single cells. The tumor cells are small and uniform.
20X
Solid pseudopapillary tumor,
Pancreas FNA, Direct Smear.
The aspirates show neoplastic epithelioid cells clinging to the branching capillary vasculatures as well as dispersed single cells. The tumor cells are small and uniform.
20X

Solid pseudopapillary tumor,
Pancreas FNA, Direct Smear.
At a higher magnification, the tumor cells have indistinct cell borders and oval nuclei with nuclear grooves, fine chromatin and small nucleoli.
40X
Solid pseudopapillary tumor,
Pancreas FNA, Direct Smear.
At a higher magnification, the tumor cells have indistinct cell borders and oval nuclei with nuclear grooves, fine chromatin and small nucleoli.
40X

Solid pseudopapillary tumor,
Pancreas FNA, Cell Block.
The tumor shows pseudopapillae with hyalinized fibrovascular cores lined by several layers of bland epithelioid cells.
20X
Solid pseudopapillary tumor,
Pancreas FNA, Cell Block.
The tumor shows pseudopapillae with hyalinized fibrovascular cores lined by several layers of bland epithelioid cells.
20X

Solid pseudopapillary tumor,
Pancreas FNA, Cell Block.
In cross section, the papillae have a rosette-like appearance (middle upper). The tumor cells have eosinophilic cytoplasm and oval nuclei with nuclear grooves and small nucleoli.
40X
Solid pseudopapillary tumor,
Pancreas FNA, Cell Block.
In cross section, the papillae have a rosette-like appearance (middle upper). The tumor cells have eosinophilic cytoplasm and oval nuclei with nuclear grooves and small nucleoli.
40X

Solid pseudopapillary tumor,
Pancreas FNA, Cell Block.
Immunocytochemically, the tumor is negative for cytokeratin (AE1/AE3), a finding that can be useful for excluding other cytologically bland tumors, such as pancreatic neuroendocrine neoplasms, acinar cell carcinoma and serous cystadenoma.
40X
Solid pseudopapillary tumor,
Pancreas FNA, Cell Block.
Immunocytochemically, the tumor is negative for cytokeratin (AE1/AE3), a finding that can be useful for excluding other cytologically bland tumors, such as pancreatic neuroendocrine neoplasms, acinar cell carcinoma and serous cystadenoma.
40X

Solid pseudopapillary tumor,
Pancreas FNA, Cell Block.
The tumor shows strong immunoreactivity with vimentin.
40X
Solid pseudopapillary tumor,
Pancreas FNA, Cell Block.
The tumor shows strong immunoreactivity with vimentin.
40X

Solid pseudopapillary tumor,
Pancreas FNA, Cell Block.
The beta-catenin immunostain shows both cytoplasmic and nuclear staining in the tumor cells.
40X
Solid pseudopapillary tumor,
Pancreas FNA, Cell Block.
The beta-catenin immunostain shows both cytoplasmic and nuclear staining in the tumor cells.
40X
Serous Cystadenoma

Serous cystadenoma,
Pancreas FNA, ThinPrep.
The aspirates are often paucicellular and show a few groups of monolayered bland epithelial cells with round nuclei. Scattered histiocytes are seen in the background.
40X
Serous cystadenoma,
Pancreas FNA, ThinPrep.
The aspirates are often paucicellular and show a few groups of monolayered bland epithelial cells with round nuclei. Scattered histiocytes are seen in the background.
40X

Serous cystadenoma,
Pancreas FNA, Cell Block.
Strips of bland epithelial cells are present. The tumor cells are cuboidal and have clear to eosinophilic cytoplasm and round nuclei. No intracytoplasmic mucin is present.
40X
Serous cystadenoma,
Pancreas FNA, Cell Block.
Strips of bland epithelial cells are present. The tumor cells are cuboidal and have clear to eosinophilic cytoplasm and round nuclei. No intracytoplasmic mucin is present.
40X

Serous cystadenoma,
Pancreas FNA, Cell Block.
Strips of tumor cells are present with scattered histiocytes and cellular debris.
40X
Serous cystadenoma,
Pancreas FNA, Cell Block.
Strips of tumor cells are present with scattered histiocytes and cellular debris.
40X
Mucinous Cystadenoma

Mucinous cystadenoma,
Pancreas FNA, Direct Smear.
The aspirates are often paucicellular and show cohesive groups of bland epithelial cells arranged in a monolayer fashion. Intracytoplasmic mucin is appreciated in the tumor cells (lower edge). The appearance can be indistinguishable from gastric foveolar mucosal contamination (see introductory text).
40X
Mucinous cystadenoma,
Pancreas FNA, Direct Smear.
The aspirates are often paucicellular and show cohesive groups of bland epithelial cells arranged in a monolayer fashion. Intracytoplasmic mucin is appreciated in the tumor cells (lower edge). The appearance can be indistinguishable from gastric foveolar mucosal contamination (see introductory text).
40X

Mucinous cystadenoma,
Pancreas FNA, Cell Block.
Strips of columnar epithelial cells retain a two-dimensional flat arrangement but the nuclei are at haphazard locations relative to the basal or apical cytoplasm, without evidence of reactive features or inflammation. This degree of disarray would be highly unusual for normal, uninflammed gastric mucosa. Apical mucin vacuoles are seen in some of tumor cells. The absence of significant pleomorphism and the absence of stratification (multilayering) of the epithelium rules out high grade dysplasia in this sample.
40X
Mucinous cystadenoma,
Pancreas FNA, Cell Block.
Strips of columnar epithelial cells retain a two-dimensional flat arrangement but the nuclei are at haphazard locations relative to the basal or apical cytoplasm, without evidence of reactive features or inflammation. This degree of disarray would be highly unusual for normal, uninflammed gastric mucosa. Apical mucin vacuoles are seen in some of tumor cells. The absence of significant pleomorphism and the absence of stratification (multilayering) of the epithelium rules out high grade dysplasia in this sample.
40X
Intraductal Papillary Mucinous Neoplasm

Intraductal papillary mucinous neoplasm #1,
Pancreas FNA, Direct Smear.
The aspirates show a small group of tall bland columnar epithelial cells in a background of mucin. A few histiocytes are present.
40X
Intraductal papillary mucinous neoplasm #1,
Pancreas FNA, Direct Smear.
The aspirates show a small group of tall bland columnar epithelial cells in a background of mucin. A few histiocytes are present.
40X

Intraductal papillary mucinous neoplasm #1,
Pancreas FNA, Cell Block.
The tumor cells form glandular and papillary structures. Histiocytes are seen between epithelial groups. Compared to Figure 79, there is a greater degree of pseudostratification (nuclei at various positions in the cytoplasm in a monolayered epithelium). The pseudostratification is most marked at the very right and the very top of the figure. There is no significant pleomorphism and no true stratification or multilayering of cells on top of each other. These features are consistent with an IPMN without high grade dysplasia in this sample.
20X
Intraductal papillary mucinous neoplasm #1,
Pancreas FNA, Cell Block.
The tumor cells form glandular and papillary structures. Histiocytes are seen between epithelial groups. Compared to Figure 79, there is a greater degree of pseudostratification (nuclei at various positions in the cytoplasm in a monolayered epithelium). The pseudostratification is most marked at the very right and the very top of the figure. There is no significant pleomorphism and no true stratification or multilayering of cells on top of each other. These features are consistent with an IPMN without high grade dysplasia in this sample.
20X

Intraductal papillary mucinous neoplasm #1,
Pancreas FNA, Cell Block.
Higher magnification of Figure 81 shows prominent true papillary formation with fibrovascular cores lined by pseudostratified columnar cells. The epithelial cells have prominent intracytoplasmic mucin.
40X
Intraductal papillary mucinous neoplasm #1,
Pancreas FNA, Cell Block.
Higher magnification of Figure 81 shows prominent true papillary formation with fibrovascular cores lined by pseudostratified columnar cells. The epithelial cells have prominent intracytoplasmic mucin.
40X

Intraductal papillary mucinous neoplasm #2,
Pancreas FNA, Direct Smear.
The aspirates show clusters of columnar epithelial cells in a background of mucin-like material, histiocytes and cellular debris. A few single columnar cells are also present. It can be difficult in a monolayer preparation to determine if this is neoplastic or normal GI mucosa or, if neoplastic, the degree of dysplasia.
40X
Intraductal papillary mucinous neoplasm #2,
Pancreas FNA, Direct Smear.
The aspirates show clusters of columnar epithelial cells in a background of mucin-like material, histiocytes and cellular debris. A few single columnar cells are also present. It can be difficult in a monolayer preparation to determine if this is neoplastic or normal GI mucosa or, if neoplastic, the degree of dysplasia.
40X

Intraductal papillary mucinous neoplasm #2,
Pancreas FNA, Direct Smear.
The tumor cells are columnar in variably shaped clusters of primarily two-dimensional sheets. Irregular spacing of nuclei is present and there is probable pseudostratification. It can be difficult to exclude high grade dysplasia in this direct smear.
20X
Intraductal papillary mucinous neoplasm #2,
Pancreas FNA, Direct Smear.
The tumor cells are columnar in variably shaped clusters of primarily two-dimensional sheets. Irregular spacing of nuclei is present and there is probable pseudostratification. It can be difficult to exclude high grade dysplasia in this direct smear.
20X

Intraductal papillary mucinous neoplasm #2,
Pancreas FNA, Direct Smear.
The tumor cells are present as a papillary cluster with a fibrovascular core. The tumor cells show some variation in size and shape and prominent pseudostratification. It is difficult to estimate the degree of histologic dysplasia in a monolayer such as this. The degree of dysplasia is important because (histological) high grade dysplasia is often considered an indication for resection.
40X
Intraductal papillary mucinous neoplasm #2,
Pancreas FNA, Direct Smear.
The tumor cells are present as a papillary cluster with a fibrovascular core. The tumor cells show some variation in size and shape and prominent pseudostratification. It is difficult to estimate the degree of histologic dysplasia in a monolayer such as this. The degree of dysplasia is important because (histological) high grade dysplasia is often considered an indication for resection.
40X

Intraductal papillary mucinous neoplasm #2,
Pancreas FNA, Cell Block.
The group on the left is a stripped true papillary group because the apical cytoplasm is facing outward. A small group of tumor cells with mild cytological atypia is seen (right).
40X
Intraductal papillary mucinous neoplasm #2,
Pancreas FNA, Cell Block.
The group on the left is a stripped true papillary group because the apical cytoplasm is facing outward. A small group of tumor cells with mild cytological atypia is seen (right).
40X

Intraductal papillary mucinous neoplasm #3,
Pancreas FNA, Direct Smear.
The aspirates show clusters of neoplastic columnar epithelial cells. The tumor cells show irregular nuclear spacing with only mild pleomorphism.
20X
Intraductal papillary mucinous neoplasm #3,
Pancreas FNA, Direct Smear.
The aspirates show clusters of neoplastic columnar epithelial cells. The tumor cells show irregular nuclear spacing with only mild pleomorphism.
20X

Intraductal papillary mucinous neoplasm #3,
Pancreas FNA, Direct Smear.
However, some of the tumor cells are large, pleomorphic and present as single cells as well as disorganized, stratified groups. These findings are consistent with high-grade dysplasia or malignant transformation of this intraductal papillary neoplasm.
40X
Intraductal papillary mucinous neoplasm #3,
Pancreas FNA, Direct Smear.
However, some of the tumor cells are large, pleomorphic and present as single cells as well as disorganized, stratified groups. These findings are consistent with high-grade dysplasia or malignant transformation of this intraductal papillary neoplasm.
40X

Intraductal papillary mucinous neoplasm #3,
Pancreas FNA, Direct Smear.
The tumor cells have cytoplasmic vacuoles, irregular nuclear contours and small nucleoli. There is no definite stratification and only mild pleomorphism. The findings are not definitive as to the degree of dysplasia.
40X
Intraductal papillary mucinous neoplasm #3,
Pancreas FNA, Direct Smear.
The tumor cells have cytoplasmic vacuoles, irregular nuclear contours and small nucleoli. There is no definite stratification and only mild pleomorphism. The findings are not definitive as to the degree of dysplasia.
40X

Intraductal papillary mucinous neoplasm #3,
Pancreas FNA, Cell Block.
The tumor cells have high nuclear to cytoplasmic ratio and hyperchromatic nuclei and form papillary architectures. The cigar-shaped nuclei are indicative of the “intestinal type” of IPMN, according to the WHO classification, and there is focal true stratification indicative of high grade dysplasia.
20X
Intraductal papillary mucinous neoplasm #3,
Pancreas FNA, Cell Block.
The tumor cells have high nuclear to cytoplasmic ratio and hyperchromatic nuclei and form papillary architectures. The cigar-shaped nuclei are indicative of the “intestinal type” of IPMN, according to the WHO classification, and there is focal true stratification indicative of high grade dysplasia.
20X

Intraductal papillary mucinous neoplasm #3,
Pancreas FNA, Cell Block.
Higher magnification of Figure 90 shows glandular complexity, resembling a cribriform growth pattern (center). Focal tumor necrosis is seen (middle lower).
40X
Intraductal papillary mucinous neoplasm #3,
Pancreas FNA, Cell Block.
Higher magnification of Figure 90 shows glandular complexity, resembling a cribriform growth pattern (center). Focal tumor necrosis is seen (middle lower).
40X
Non-Hodgkin B-Cell Lymphoma

Non-Hodgkin B-cell lymphoma,
Pancreas FNA, Direct Smear.
The aspirates show dispersed single intermediate to large atypical lymphocytes.
20X
Non-Hodgkin B-cell lymphoma,
Pancreas FNA, Direct Smear.
The aspirates show dispersed single intermediate to large atypical lymphocytes.
20X

Non-Hodgkin B-cell lymphoma,
Pancreas FNA, Direct Smear.
At a higher magnification, the atypical lymphocytes show variations in size and shape. Scattered lymphoglandular bodies are seen in the background.
40X
Non-Hodgkin B-cell lymphoma,
Pancreas FNA, Direct Smear.
At a higher magnification, the atypical lymphocytes show variations in size and shape. Scattered lymphoglandular bodies are seen in the background.
40X

Non-Hodgkin B-cell lymphoma,
Pancreas FNA, Cell Block.
Atypical lymphoid infiltrates are present in fibrotic tissue fragment. The atypical cells are intermediate to large in size and have irregular nuclear contours and conspicuous nucleoli. Flow cytometry of the aspirates demonstrates a monoclonal B-cell lymphoma. Overall, the findings are consistent with diffuse large B-cell lymphoma.
40X
Non-Hodgkin B-cell lymphoma,
Pancreas FNA, Cell Block.
Atypical lymphoid infiltrates are present in fibrotic tissue fragment. The atypical cells are intermediate to large in size and have irregular nuclear contours and conspicuous nucleoli. Flow cytometry of the aspirates demonstrates a monoclonal B-cell lymphoma. Overall, the findings are consistent with diffuse large B-cell lymphoma.
40X
Plasma Cell Neoplasm

Plasma cell neoplasm,
Pancreas FNA, Direct Smear.
The aspirates show dispersed single cells with a prominent plasmacytoid appearance. The tumor cells vary slightly in size. Rare mitoses are seen.
20X
Plasma cell neoplasm,
Pancreas FNA, Direct Smear.
The aspirates show dispersed single cells with a prominent plasmacytoid appearance. The tumor cells vary slightly in size. Rare mitoses are seen.
20X

Plasma cell neoplasm,
Pancreas FNA, Direct Smear.
The tumor cells show perinuclear hof (clearing). Binucleated tumor cells are occasionally seen. Scattered lymphoglandular bodies are seen in the background.
40X
Plasma cell neoplasm,
Pancreas FNA, Direct Smear.
The tumor cells show perinuclear hof (clearing). Binucleated tumor cells are occasionally seen. Scattered lymphoglandular bodies are seen in the background.
40X

Plasma cell neoplasm,
Pancreas FNA, Direct Smear.
The tumor cells have eccentrically located round nuclei with clumped chromatin and small nucleoli.
40X
Plasma cell neoplasm,
Pancreas FNA, Direct Smear.
The tumor cells have eccentrically located round nuclei with clumped chromatin and small nucleoli.
40X

Plasma cell neoplasm,
Pancreas FNA, Cell Block.
Single tumor cells show eccentric nuclei and occasional binucleation. Flow cytometry demonstrate CD38 positive B-cells without surface immunoglobulin expression. The cytomorphologic features along with flow cytometry results are consistent with plasma cell neoplasm. CD138 immunostain can be performed on the cell block section to support the diagnosis if needed.
40X
Plasma cell neoplasm,
Pancreas FNA, Cell Block.
Single tumor cells show eccentric nuclei and occasional binucleation. Flow cytometry demonstrate CD38 positive B-cells without surface immunoglobulin expression. The cytomorphologic features along with flow cytometry results are consistent with plasma cell neoplasm. CD138 immunostain can be performed on the cell block section to support the diagnosis if needed.
40X
Metastatic Lesions
Lung

Metastatic adenocarcinoma of the lung,
Pancreas FNA, Direct Smear.
The aspirates show single and clusters of malignant epithelial cells. The tumor cells are large and pleomorphic. The appearance could be compatible with a pancreatic primary. Clinical correlation or immunostains would be necessary to make the distinction from a metastasis from the patient’s known lung cancer.
20X
Metastatic adenocarcinoma of the lung,
Pancreas FNA, Direct Smear.
The aspirates show single and clusters of malignant epithelial cells. The tumor cells are large and pleomorphic. The appearance could be compatible with a pancreatic primary. Clinical correlation or immunostains would be necessary to make the distinction from a metastasis from the patient’s known lung cancer.
20X

Metastatic adenocarcinoma of the lung,
Pancreas FNA, Direct Smear.
At a higher magnification, the tumor cells have vacuolated cytoplasm and round nuclei with prominent nucleoli.
40X
Metastatic adenocarcinoma of the lung,
Pancreas FNA, Direct Smear.
At a higher magnification, the tumor cells have vacuolated cytoplasm and round nuclei with prominent nucleoli.
40X

Metastatic adenocarcinoma of the lung,
Pancreas FNA, Cell Block.
The tumor cells are large, pleomorphic and present as disorganized sheets.
40X
Metastatic adenocarcinoma of the lung,
Pancreas FNA, Cell Block.
The tumor cells are large, pleomorphic and present as disorganized sheets.
40X

Metastatic adenocarcinoma of the lung,
Pancreas FNA, Cell Block.
(Same case as Figures 99-101) The tumor cells are diffusely positive for TTF-1, indicative of a lung primary.
40X
Metastatic adenocarcinoma of the lung,
Pancreas FNA, Cell Block.
(Same case as Figures 99-101) The tumor cells are diffusely positive for TTF-1, indicative of a lung primary.
40X

Metastatic small cell carcinoma of the lung,
Pancreas FNA, Direct Smear.
The aspirates show single and clusters of malignant epithelial cells. The tumor cells are intermediate in size and have scant cytoplasm. Nuclear molding is readily seen.
40X
Metastatic small cell carcinoma of the lung,
Pancreas FNA, Direct Smear.
The aspirates show single and clusters of malignant epithelial cells. The tumor cells are intermediate in size and have scant cytoplasm. Nuclear molding is readily seen.
40X

Metastatic small cell carcinoma of the lung,
Pancreas FNA, Direct Smear.
The tumor cells have speckled (“salt and pepper”) chromatin and inconspicuous nucleoli with smearing crush artifact (nuclear streaming). Scattered apoptotic bodies are seen in the background.
40X
Metastatic small cell carcinoma of the lung,
Pancreas FNA, Direct Smear.
The tumor cells have speckled (“salt and pepper”) chromatin and inconspicuous nucleoli with smearing crush artifact (nuclear streaming). Scattered apoptotic bodies are seen in the background.
40X

Metastatic small cell carcinoma of the lung,
Pancreas FNA, Cell Block.
The tumor cells with high nuclear to cytoplasmic ratios are present as structureless sheets. Tumor necrosis is present.
20X
Metastatic small cell carcinoma of the lung,
Pancreas FNA, Cell Block.
The tumor cells with high nuclear to cytoplasmic ratios are present as structureless sheets. Tumor necrosis is present.
20X

Metastatic small cell carcinoma of the lung,
Pancreas FNA, Cell Block.
The tumor cells have scant cytoplasm, speckled (“salt and pepper”) chromatin and inconspicuous nucleoli. A few mitoses are seen.
40X
Metastatic small cell carcinoma of the lung,
Pancreas FNA, Cell Block.
The tumor cells have scant cytoplasm, speckled (“salt and pepper”) chromatin and inconspicuous nucleoli. A few mitoses are seen.
40X

Metastatic small cell carcinoma of the lung,
Pancreas FNA, Cell Block.
The tumor cells show cytoplasmic staining for synaptophysin supporting a neuroendocrine differentiation.
40X
Metastatic small cell carcinoma of the lung,
Pancreas FNA, Cell Block.
The tumor cells show cytoplasmic staining for synaptophysin supporting a neuroendocrine differentiation.
40X

Metastatic small cell carcinoma of the lung,
Pancreas FNA, Cell Block.
The tumor cells are positive for TTF-1 (nuclear staining). Given the patient’s clinical presentation of a large hilar lung mass and associated mediastinal lymphadenopathy, the findings are consistent with a lung metastasis.
40X
Metastatic small cell carcinoma of the lung,
Pancreas FNA, Cell Block.
The tumor cells are positive for TTF-1 (nuclear staining). Given the patient’s clinical presentation of a large hilar lung mass and associated mediastinal lymphadenopathy, the findings are consistent with a lung metastasis.
40X
Colon

Metastatic adenocarcinoma of the colon,
Pancreas FNA, Direct Smear.
The aspirates show clusters of malignant epithelial cells in a background of necrosis. The tumor cells are large and columnar with high nuclear to cytoplasmic ratios.
20X
Metastatic adenocarcinoma of the colon,
Pancreas FNA, Direct Smear.
The aspirates show clusters of malignant epithelial cells in a background of necrosis. The tumor cells are large and columnar with high nuclear to cytoplasmic ratios.
20X

Metastatic adenocarcinoma of the colon,
Pancreas FNA, Direct Smear.
The tumor cells have enlarged oval nuclei with irregular nuclear contours, clumped chromatin and conspicuous nucleoli. Glandular structures are readily seen. The appearance could be compatible with a pancreatic primary. Immunohistochemical studies and clinical correlation can be essential to distinguish a metastasis to the pancreas.
40X
Metastatic adenocarcinoma of the colon,
Pancreas FNA, Direct Smear.
The tumor cells have enlarged oval nuclei with irregular nuclear contours, clumped chromatin and conspicuous nucleoli. Glandular structures are readily seen. The appearance could be compatible with a pancreatic primary. Immunohistochemical studies and clinical correlation can be essential to distinguish a metastasis to the pancreas.
40X

Metastatic adenocarcinoma of the colon,
Pancreas FNA, Cell Block.
Large columnar tumor cells with hyperchromatic nuclei form sheets and glands. Pseudostratification as well as true stratification is seen. Abundant necrosis is also present.
20X
Metastatic adenocarcinoma of the colon,
Pancreas FNA, Cell Block.
Large columnar tumor cells with hyperchromatic nuclei form sheets and glands. Pseudostratification as well as true stratification is seen. Abundant necrosis is also present.
20X

Metastatic adenocarcinoma of the colon,
Pancreas FNA, Cell Block.
The tumor cells forming the glands are large, pleomorphic and have hyperchromatic nuclei with irregular nuclear contours and conspicuous nucleoli. Abundant necrosis is also present.
40X
Metastatic adenocarcinoma of the colon,
Pancreas FNA, Cell Block.
The tumor cells forming the glands are large, pleomorphic and have hyperchromatic nuclei with irregular nuclear contours and conspicuous nucleoli. Abundant necrosis is also present.
40X

Metastatic adenocarcinoma of the colon,
Pancreas FNA, Cell Block.
The tumor cells are positive for CDX-2 (nuclear staining). This finding along with keratin 20 immunopositivity and the cytomorphologic features supports a colorectal primary.
10X
Metastatic adenocarcinoma of the colon,
Pancreas FNA, Cell Block.
The tumor cells are positive for CDX-2 (nuclear staining). This finding along with keratin 20 immunopositivity and the cytomorphologic features supports a colorectal primary.
10X
Renal

Metastatic renal cell carcinoma,
Pancreas FNA, Direct Smear.
The aspirates show large three-dimensional clusters of malignant epithelial cells in a bloody background. The tumor cells have vacuolated cytoplasm.
20X
Metastatic renal cell carcinoma,
Pancreas FNA, Direct Smear.
The aspirates show large three-dimensional clusters of malignant epithelial cells in a bloody background. The tumor cells have vacuolated cytoplasm.
20X

Metastatic renal cell carcinoma,
Pancreas FNA, Direct Smear.
The tumor cells are large and have abundant vacuolated cytoplasm and round nuclei.
40X
Metastatic renal cell carcinoma,
Pancreas FNA, Direct Smear.
The tumor cells are large and have abundant vacuolated cytoplasm and round nuclei.
40X

Metastatic renal cell carcinoma,
Pancreas FNA, Direct Smear.
The tumor cells have round to oval nuclei with fine chromatin and conspicuous nucleoli, forming three-dimensional clusters. Slender endothelial cell nuclei (from capillary vessels) are seen with the clusters.
40X
Metastatic renal cell carcinoma,
Pancreas FNA, Direct Smear.
The tumor cells have round to oval nuclei with fine chromatin and conspicuous nucleoli, forming three-dimensional clusters. Slender endothelial cell nuclei (from capillary vessels) are seen with the clusters.
40X

Metastatic renal cell carcinoma,
Pancreas FNA, Cell Block.
The typical clear cytoplasm and organoid growth pattern with a delicate capillary network of a clear cell carcinoma are readily apparent. Immunohistochemical markers (RCC, CD10, pan-keratin, vimentin and absence of keratins 7 and 20) can be helpful to pinpoint the diagnosis.
40X
Metastatic renal cell carcinoma,
Pancreas FNA, Cell Block.
The typical clear cytoplasm and organoid growth pattern with a delicate capillary network of a clear cell carcinoma are readily apparent. Immunohistochemical markers (RCC, CD10, pan-keratin, vimentin and absence of keratins 7 and 20) can be helpful to pinpoint the diagnosis.
40X
High Grade Sarcoma

Metastatic high-grade sarcoma,
Pancreas FNA, Direct Smear.
The aspirates show scattered malignant cells, predominantly present as single cells. The tumor cells are large and pleomorphic. Binucleated tumor cells are occasionally seen. The differential diagnosis for these cytologic features is broad.
40X
Metastatic high-grade sarcoma,
Pancreas FNA, Direct Smear.
The aspirates show scattered malignant cells, predominantly present as single cells. The tumor cells are large and pleomorphic. Binucleated tumor cells are occasionally seen. The differential diagnosis for these cytologic features is broad.
40X

Metastatic high-grade sarcoma,
Pancreas FNA, Direct Smear.
The tumor cells have high nuclear to cytoplasmic ratios and large nucleoli. A group of benign pancreatic ductal cells is seen (right).
40X
Metastatic high-grade sarcoma,
Pancreas FNA, Direct Smear.
The tumor cells have high nuclear to cytoplasmic ratios and large nucleoli. A group of benign pancreatic ductal cells is seen (right).
40X

Metastatic high-grade sarcoma,
Pancreas FNA, Cell Block.
Large pleomorphic tumor cells are present singly or in small groups. Tumor necrosis is seen.
40X
Metastatic high-grade sarcoma,
Pancreas FNA, Cell Block.
Large pleomorphic tumor cells are present singly or in small groups. Tumor necrosis is seen.
40X

Metastatic high-grade sarcoma,
Pancreas FNA, Cell Block.
The tumor cells show positive staining for vimentin.
40X
Metastatic high-grade sarcoma,
Pancreas FNA, Cell Block.
The tumor cells show positive staining for vimentin.
40X

Metastatic high-grade sarcoma,
Pancreas FNA, Cell Block.
Cytokeratin (AE1/AE3) immunostain is negative in tumor cells. The patient has a known history of high-grade sarcoma of the right thigh. Overall, the findings support the diagnosis of metastatic high-grade sarcoma.
40X
Metastatic high-grade sarcoma,
Pancreas FNA, Cell Block.
Cytokeratin (AE1/AE3) immunostain is negative in tumor cells. The patient has a known history of high-grade sarcoma of the right thigh. Overall, the findings support the diagnosis of metastatic high-grade sarcoma.
40X
References
- Layfield LJ, Jarboe EA. Cytopathology of the pancreas: neoplastic and nonneoplastic entities. Annals of Diagnostic Pathology 2010; 14:140-151.
- Raut CP, Grau AM, Staerkel GA, Kaw M, Tamm EP, Wolff RA, Vauthey JN, Lee JE, Pisters PW, Evans DB. Diagnostic accuracy of endoscopic ultrasound-guided fine-needle aspiration in patients with presumed pancreatic cancer. Journal of Gastrointestinal Surgery 2003; 7:118-128.
- O’Toole D, Palazzo L, Arotcarena R, Dancour A, Aubert A, Hammel P, Amaris J, Ruszniewski P. Assessment of complications of EUS-guided fine-needle aspiration. Gastrointestinal Endoscopy 2001; 53:470-474.
- Bentz JS, Kochman ML, Faigel DO, Ginsberg GG, Smith DB, Gupta PK. Endoscopic ultrasound-guided real-time fine-needle aspiration: clinicopathologic features of 60 patients. Diagnostic Cytopathology 1998; 18:98-109.
- David O, Green L, Reddy V, Kluskens L, Bitterman P, Attal H, Prinz R, Gattuso P. Pancreatic masses: a multi-institutional study of 364 fine-needle aspiration biopsies with histopathologic correlation. Diagnostic Cytopathology 1998; 19:423-427.
- Shin HJ, Lahoti S, Sneige N. Endoscopic ultrasound-guided fine-needle aspiration in 179 cases: the M. D. Anderson Cancer Center experience. Cancer Cytopathology 2002; 96:174-180.
- Mitsuhashi T, Ghafari S, Chang CY, Gu M. Endoscopic ultrasound-guided fine needle aspiration of the pancreas: cytomorphological evaluation with emphasis on adequacy assessment, diagnostic criteria and contamination from the gastrointestinal tract. Cytopathology 2006; 17:34-41.
- Klapman JB, Logrono R, Dye CE, Waxman I. Clinical impact of on-site cytopathology interpretation on endoscopic ultrasound-guided fine needle aspiration. American Journal of Gastroenterology 2003; 98:1289-1294.
- Brugge WR, Lewandrowski K, Lee-Lewandrowski E, Centeno BA, Szydlo T, Regan S, del Castillo CF, Warshaw AL. Diagnosis of pancreatic cystic neoplasms: a report of the cooperative pancreatic cyst study. Gastroenterology 2004; 126:1330-1336.
- Volmar KE, Creager AJ. Fine needle aspiration of pancreatic cysts: Use of ancillary studies and difficulty in identifying surgical candidates. Acta Cytologica 2006; 50:647-655.
- Pitman MB, Lewandrowski K, Shen J, Sahani D, Brugge W, Fernandez-del Castillo C. Pancreatic cysts: preoperative diagnosis and clinical management. Cancer Cytopathology 2010; 118:1-13.
- Shen J, Brugge WR, Dimaio CJ, Pitman MB. Molecular analysis of pancreatic cyst fluid: a comparative analysis with current practice of diagnosis. Cancer Cytopathology 2009; 117:217-227.
- Sreenarasimhaiah J, Lara LF, Jazrawi SF, Barnett CC, Tang SJ. A comparative analysis of pancreas cyst fluid CEA and histology with DNA mutational analysis in the detection of mucin producing or malignant cysts. Journal of the Pancreas 2009; 10:163-168.
- Stelow EB, Bardales RH, Lai R, Mallery S, Linzie BM, Crary GS, Stanley MW. The cytological spectrum of chronic pancreatitis. Diagnostic Cytopathology 2005; 32:65-69.
- Jarboe EA, Layfield LJ. Cytologic features of pancreatic intraepithelial neoplasia and pancreatitis: potential pitfalls in the diagnosis of pancreatic ductal carcinoma. Diagnostic Cytopathology 2011; 39:575-581.
- Yantiss RK, Cosar E, Fischer AH. Use of IMP3 in identification of carcinoma in fine needle aspiration biopsies of pancreas. Acta Cytologica 2008; 52:133-138.
- Giorgadze TA, Peterman H, Baloch ZW, Furth EE, Pasha T, Shiina N, Zhang PJ, Gupta PK. Diagnostic utility of mucin profile in fine-needle aspiration specimens of the pancreas: an immunohistochemical study with surgical pathology correlation. Cancer Cytopathology 2006; 108:186-197.
- Kopelman Y, Marmor S, Ashkenazi I, Fireman Z. Value of EUS-FNA cytological preparations compared with cell block sections in the diagnosis of pancreatic solid tumours. Cytopathology 2011; 22:174-178.
- Stelow EB, Bardales RH, Shami VM, Woon C, Presley A, Mallery S, Lai R, Stanley MW. Cytology of pancreatic acinar cell carcinoma. Diagnostic Cytopathology 2006; 34:367-372.
- Bardales RH, Centeno B, Mallery JS, Lai R, Pochapin M, Guiter G, Stanley MW. Endoscopic ultrasound-guided fine-needle aspiration cytology diagnosis of solid-pseudopapillary tumor of the pancreas: a rare neoplasm of elusive origin but characteristic cytomorphologic features. American Journal of Clinical Pathology 2004; 121:654-662.
- Gu M, Ghafari S, Lin F, Ramzy I. Cytological diagnosis of endocrine tumors of the pancreas by endoscopic ultrasound-guided fine-needle aspiration biopsy. Diagnostic Cytopathology 2005; 32:204-210.
- Chatzipantelis P, Salla C, Konstantinou P, Karoumpalis I, Sakellariou S, Doumani I. Endoscopic ultrasound-guided fine-needle aspiration cytology of pancreatic neuroendocrine tumors: a study of 48 cases. Cancer Cytopathology 2008; 114:255-262.
- Jani N, Dewitt J, Eloubeidi M, Varadarajulu S, Appalaneni V, Hoffman B, Brugge W, Lee K, Khalid A, McGrath K. Endoscopic ultrasound-guided fine-needle aspiration for diagnosis of solid pseudopapillary tumors of the pancreas: a multicenter experience. Endoscopy 2008; 40:200-203.
- Burford H, Baloch Z, Liu X, Jhala D, Siegal GP, Jhala N. E-cadherin/beta-catenin and CD10: a limited immunohistochemical panel to distinguish pancreatic endocrine neoplasm from solid pseudopapillary neoplasm of the pancreas on endoscopic ultrasound-guided fine-needle aspirates of the pancreas. American Journal of Clinical Pathology 2009; 132:831-839.
- Layfield LJ, Cramer H. Fine-needle aspiration cytology of intraductal papillary-mucinous tumors: a retrospective analysis. Diagnostic Cytopathology 2005; 32:16-20.
- Maire F, Couvelard A, Hammel P, Ponsot P, Palazzo L, Aubert A, Degott C, Dancour A, Felce-Dachez M, O’toole D, Levy P, Ruszniewski P. Intraductal papillary mucinous tumors of the pancreas: the preoperative value of cytologic and histopathologic diagnosis. Gastrointestinal Endoscopy 2003; 58:701-706.
- Pitman MB, Genevay M, Yaeger K, Chebib I, Turner BG, Mino-Kenudson M, Brugge WR. (2010). “High-grade atypical epithelial cells in pancreatic mucinous cysts are a more accurate predictor of malignancy than “positive” cytology.” Cancer Cytopathology 118(6): 434-440.
- (2010). World Health Organization Classification of Tumors of the Digestive System. 4th edition, 2010, Published by the International Agency for Research on Cancer (IARC). Lyon, France.
- Maire F, Voitot H, Aubert A, Palazzo L, O’Toole D, Couvelard A, Levy P, Vidaud M, Sauvanet A, Ruszniewski P, Hammel P. Intraductal papillary mucinous neoplasms of the pancreas: performance of pancreatic fluid analysis for positive diagnosis and the prediction of malignancy. American Journal of Gastroenterology 2008; 103:2871-2877.
- Huang P, Staerkel G, Sneige N, Gong Y. Fine-needle aspiration of pancreatic serous cystadenoma: cytologic features and diagnostic pitfalls. Cancer Cytopathology 2006; 108(4):239-249.
- Belsley NA, Pitman MB, Lauwers GY, Brugge WR, Deshpande V. Serous cystadenoma of the pancreas: limitations and pitfalls of endoscopic ultrasound-guided fine-needle aspiration biopsy. Cancer Cytopathology 2008; 114:102-110.
- Recine M, Kaw M, Evans DB, Krishnamurthy S. Fine-needle aspiration cytology of mucinous tumors of the pancreas. Cancer Cytopathology 2004; 102:92-99.
- Volmar KE, Jones CK, Xie HB. Metastases in the pancreas from nonhematologic neoplasms: report of 20 cases evaluated by fine-needle aspiration. Diagnostic Cytopathology 2004; 31:216-220.
- Mesa H, Stelow EB, Stanley MW, Mallery S, Lai R, Bardales RH. Diagnosis of nonprimary pancreatic neoplasms by endoscopic ultrasound-guided fine-needle aspiration. Diagnostic Cytopathology 2004; 31:313-318.
- DeWitt J, Jowell P, Leblanc J, McHenry L, McGreevy K, Cramer H, Volmar K, Sherman S, Gress F. EUS-guided FNA of pancreatic metastases: a multicenter experience. Gastrointestinal Endoscopy 2005; 61:689-696.
- Varghese L, Ngae MY, Wilson AP, Crowder CD, Gulbahce HE, Pambuccian SE. Diagnosis of metastatic pancreatic mesenchymal tumors by endoscopic ultrasound-guided fine-needle aspiration. Diagnostic Cytopathology 2009; 37:792-802.
- Arcari A, Anselmi E, Bernuzzi P, Berta R, Lazzaro A, Moroni CF, Trabacchi E, Vallisa D, Vercelli A, Cavanna L. Primary pancreatic lymphoma. A report of five cases. Haematologica 2005; 90:ECR09.
- Pugh JL, Jhala NC, Eloubeidi MA, Chhieng DC, Eltoum IA, Crowe DR, Varadarajulu S, Jhala DN. Diagnosis of deep-seated lymphoma and leukemia by endoscopic ultrasound-guided fine-needle aspiration biopsy. American Journal of Clinical Pathology 2006; 125:703-709.
- Rossi ED, Larghi A, Verna EC, Martini M, Galasso D, Carnuccio A, Larocca LM, Costamagna G, Fadda G. Endoscopic ultrasound-guided fine-needle aspiration with liquid-based cytologic preparation in the diagnosis of primary pancreatic lymphoma. Pancreas 2010; 39:1299-1302
